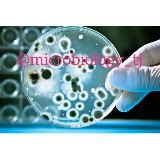
MICROBIOLOGY WORLD🌏

- Değişim
- Sandbox
- Deleted
- GIF and Video901
- IT860
- SMM7263
- Telegram8569
- Otomobil ve motosiklet6331
- Yazarın blogu2959
- Gambling601
- Şakalar154
- Anime843
- Poster229
- Business and Finance17020
- Bloggers33485
- Military258
- Çeşitli10687
- Horoscopes and Esoterica6137
- Darknet801
- Tasarım5821
- For Adults2705
- Erkekler için639
- For Parents5944
- USE and Exams9029
- Health8931
- Games16370
- Instagram1954
- Sanat6065
- Catalog231
- Coronavirus235
- Красота и мода19350
- Cryptocurrencies15846
- Cooking8591
- İpuçları202
- Dilbilim3839
- Literature7519
- Stores and Sales16805
- Tıp6542
- Mobile1661
- Müzik16333
- Science and Technology10226
- Real Estate1746
- Haberler39747
- Eğitim14811
- Single-line148
- Podcastler155
- Heard203
- Eğitim1528
- Politika15483
- Porn25437
- Nature and Animals5877
- Predictions and Bets10022
- Proxy42
- Psikoloji13715
- Travel11287
- Karışık176404
- Regional1714
- Din9982
- Crafts2274
- Hizmetler164
- Leaks657
- Yazılım199
- Spor10552
- Çıkartmalar192
- İnşaat ve tadilat4961
- Remote Work7133
- FEM-BLM171
- Facts881
- Movies and Series11978
- Fotoğraf11145
- Freebies and Discounts1485
- Alıntılar8974
- Sohbetler69553
- Shock Content1739
- Ekoloji117
- Economy9542
- Mizah14628
- Hukuk2843
- 🇦🇲 Armenian Channels206
- 🇦🇿 Azerbaycan kanalları212
- 🇧🇾 Belarusian channels1008
- 🇬🇪 Georgian Channels47
- 🇰🇬 Kırgız kanalları621
- 🇰🇿 Kazakistan kanalları724
- 🇲🇩 Moldova kanalları48
- 🇹🇯 Tacik kanalları646
- 🇺🇦 Ukrainian channels16649
- 🇺🇿 Uzbek channels9229
«Eğitim» kategorisindeki Telegram kanalları

How to search for channels in TgramSearch
Telegram uygulamasından yapılan arama sınırlı sayıda sonuç döndürdüğü için, Telegram kanallarını aramak için üçüncü taraf çözümler kullanmak daha uygundur.
TgramSearch, 700.000'den fazla Telegram kanalını içeren bir veritabanını aramanıza ve en önemlisi, sorgunuzla eşleşen kanalların tam listesini almanıza olanak tanır.
Veritabanımızdaki Telegram kanallarının listesi sürekli güncellenmektedir. Arama yapmak için ilgilendiğiniz kategoriyi seçebilir veya arama çubuğuna sorgunuzu girebilirsiniz. Çok uzun sorgular girmemenizi öneririz; sorgu bir ila üç kelimeden, ideal olarak bir kelimeden oluşmalıdır.
Channel removal from search
Lütfen dikkat: site otomatik olarak açık kaynaklardan doldurulur ve Telegram kanalları hakkında isim, açıklama, bağlantı ve avatar dışında bilgi saklamaz. Eğer yasa dışı içerik barındıran bir Telegram kanalına rastlarsanız, lütfen site menüsünde belirtilen iletişim bilgileri üzerinden bize ulaşın. Şikayeti inceledikten sonra bu Telegram kanalını aramadan kaldıracağız.










